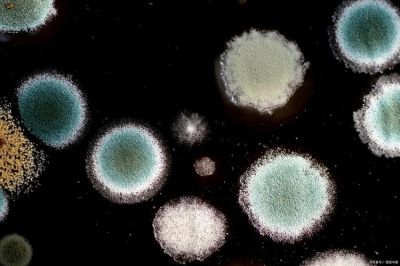

NASA与国际团队发现26种未知细菌,揭示极端微生物在无尘室的生存奥秘
时间:2025-07-28 11:10
小编:星品数码网
在高度洁净的环境中,生命的顽强力量再一次展现出惊人的韧性。日前,美国国家航空航天局(NASA)喷气推进实验室(JPL)的科学家们与印度和沙特阿拉伯的研究团队,联合在一项重要研究中发现了26种之前未知的细菌。这项研究的背景为为2007年8月发射的NASA“凤凰号”火星着陆器准备的无尘室。这些研究成果于5月12日正式发表在《Microbiome》杂志上,引起了广泛关注。
无尘室是为防止细菌及微生物在太空探测任务中入侵而特别设计的特殊环境,经过严格的消毒和控制,目的在于避免微生物“搭便车”,从而影响宇宙探测的科学性和可靠性。这次的发现让科学家们大为震惊,即使是在这种最洁净的环境中,仍然有“极端微生物”生存并繁衍生息。
参与此次研究的沙特阿拉伯阿卜杜拉国王科技大学(KAUST)的研究团队成员亚历山大·罗萨多在报告中指出:“我们的研究试图探明在未来的太空任务中,哪些微生物有可能被转移,以及这些微生物的生存能力。”这不仅对于监测和防止微生物污染至关重要,也为探索其他行星提供了新视角。
此次研究中发现的微生物,包括在海底火山、热液喷口及NASA的无尘室等极端环境中生存的细菌,充分展示了它们的生存适应性。罗萨多进一步解释,“极端微生物能够在极端的真空、辐射以及温度等恶劣条件下依然繁衍生息,其存在的意义与地球上生命的演化及生存方式密切相关。”
科学团队还在佛罗里达州肯尼迪航天中心对“凤凰号”发射前的样本进行了基因组的深入分析。这些新发现的细菌的基因组正在被细致研究,以揭示它们强大的生存能力背后的生物学机制。研究团队认为这些微生物的生存之道,与其DNA修复机制、有害物质解毒能力以及增强代谢能力都有密切的关系。
KAUST的博士后研究员朱尼亚·舒尔茨指出,“在我们新发现的细菌物种中,有一些基因在被改造后可广泛应用于医学、食品保鲜及其他工业,这有望为相关领域带来新的技术突破。”通过基因上的创新,这些微生物可能会在地球的生态系统和生物技术中扮演重要的角色。
这项研究的成果也将帮助NASA改进无尘室的相关协议,从而进一步降低未来航天任务中的生物污染风险。已退休的JPL科学家、研究的主要作者卡斯图里·文卡特斯瓦兰表示:“我们正在解读那些能够在太空恶劣条件下生存的微生物的生存之道,这不仅有助于提升航天科学的精确度,也将可能革新生命科学和生物技术的未来。”
通过这项跨国合作研究,科学家们不仅填补了在极端环境生存的生物学知识空白,还为推动微生物在生命科学及应用技术中的潜力提供了新的方向。研究人员们希望,未来的进一步探索将开启更加丰富的了解,揭开生命如何适应宇宙环境的神秘面纱。
来看,这一发现不仅为科学界提供了新的研究素材和视角,也让人类在探索宇宙的道路上增加了信心和勇气。对极端微生物的研究能够帮助我们理解生命存在的本质,进而在未来的星际探索中,增加我们对生命的认知和科学理解。人类对太空的探索虽艰难,但生命的奇迹无处不在,正如那些顽强的微生物,静静地等待着被人类发现与解读。

